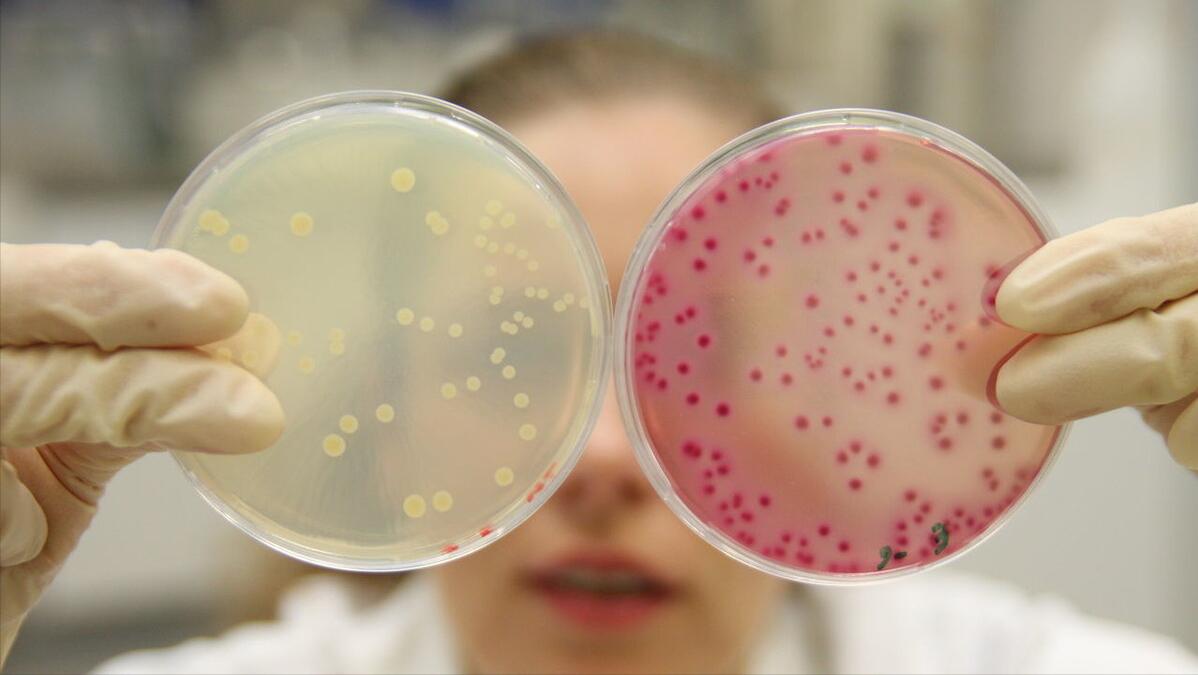
非滴虫非霉菌性阴道炎的症状表现,霉菌性阴道炎症状怎么治疗最有效

阴道长时间的潮湿闷热,是念珠菌理想的生长和繁殖环境,患病后阴道分泌物明显增多,而且有难闻的异味,天气越来越热,味道也越来越严重,即便是每天更换*裤内**,依然难以掩盖。不仅如此,还伴有剧烈瘙痒、甚至灼痛和溃疡,严重影响着女性的工作和社交,那么霉菌性阴道炎是怎么回事呢?要如何去判断呢?

一、霉菌性阴道炎是怎么回事?如何判断?
霉菌性阴道炎是一种常见的阴道炎症,致病菌为白色念珠菌,它是一种由念珠菌引起的多发性外阴道疾病。白色念珠菌在许多女性的阴道中都有寄生,但只要细菌数量不增长,就不会引发症状。而当人体的免疫力下降,或者局部的免疫力下降的时候,白色念珠菌就会借机大量繁殖,因而出现霉菌性阴道炎。
当阴道内糖原增多,酸度增高时,念珠菌可快速繁殖而引起炎症。妊娠、避孕药、抗生素、激素和免疫*制剂抑**等因素都可加速白色念珠菌的繁殖。阴道和子宫颈有病理改变时,发病率也会增高。
肥胖、甲状旁腺、甲状腺和肾上腺功能减退等也会影响念珠菌繁殖且与发病有关。此外,亦可能与大量雌激素应用、糖尿病、*交性**过频、偏嗜甜食有关。

那么,我们该如何判断霉菌性阴道炎呢?有哪些症状?
霉菌性阴道炎的病原体有80-90%是白假丝酵母菌,外阴瘙痒是霉菌性阴道炎的主要症状。初期的表现症状并不明显,一般多见于*处私**瘙痒。后期严重的话,可能会出现排尿痛、*交性**痛等现象。
除此之外,白带增多也是该病的主要症状,发作时白带变得粘稠,通常呈现豆腐渣样或者乳凝块状的异常现象。而且,有部分女性患者还可能伴随阴道粘膜红肿,严重情况甚至形成溃疡。下面,我们来具体看一下这几点症状。

1)第一个症状是外阴瘙痒。
外阴部位瘙痒严重,并时常发生。很多患者往往会出现站立不安,严重影响患者的情绪,造成患者寝食难安。
2)第二个症状是外阴红肿。
在临床上,霉菌性阴道炎患者会出现不同程度的充血现象。尤其是重度霉菌性阴道炎患者,长时间的受到细菌侵袭,而且不断的滋生细菌,往往会导致白带增多,呈现豆腐渣样的白带。外阴长时间的处在这种状态下,会造成患者外阴红肿严重,很有可能造成外阴部糜烂,表面溃疡现象。

3)第三个症状是小便时疼痛。
很多患者在小便时会感觉到明显疼痛,而且尿液发黄。同时,还会造成灼热感。典型重度患者会存在外阴糜烂,在走路时会感觉十分疼痛。
总而言之,出现霉菌性阴道炎时,需要合理地进行治疗。同时,也要注意自己的身体变化。平时应注意个人卫生,穿纯棉的宽松*裤内**,不能随意用*处私**清洗液,也不能过度清洗*处私**。

那么,有哪些原因会导致大多数女性患上霉菌性阴道炎呢?
二、为什么霉菌性阴道炎偏偏找上你?
有些女性特别爱干净,天天清洗*处私**。非常疑惑为啥还会患上阴道炎,并出现反复发作的情况。过于清洗阴道、高效消毒*裤内**,是很容易导致菌群失调,破坏微生态,让霉菌有机可趁。

所以说,女性平时要注意自己身体的清洁,身体长时间的处于潮湿而且一种密封的状态下,很容易造成局部细菌数量增多。那么有哪些原因会导致霉菌性阴道炎呢?
日常中一些女性平时喜欢乱用抗生素,抗生素在杀灭病菌的同时,也会抑制部分有益菌群,而那些没有被抑制的以及外来耐药菌就会乘机大量繁殖。此时就会很容易患上阴道炎,所以,女性在使用抗生素时一定要谨慎。

还有一些女性比较爱美,喜欢穿各种紧身裤来凸显自己的身材,比如牛仔裤。其实,紧身裤对于*处私**的影响是比较大的。这是因为它的布料选择透气性比较差,那么*处私**潮湿度就会比较大,而这种潮湿环境也会助长霉菌滋生和繁殖。
所以,大家应尽量选择透气性好、宽松的衣物,保持*处私**干燥,远离妇科疾病。

另外,还要注意夫妻生活,因为它可能会提高患霉菌性阴道炎的几率。之所以会出现这样的现象,与平时不洁的生活习惯有着密不可分的关系。一旦在进行夫妻生活的过程中不注重卫生,那么就容易滋生细菌和病毒。因此,每次同房前后都要清洗*处私**,保持个人卫生。当然,你的另一半同样需要注意这方面的卫生。

除此之外,多数女性为了避免怀孕而选择服用避孕药,殊不知避孕药对人体的伤害是非常大的。因为避孕药中的雌激素会促进霉菌生成菌丝,导致女性的*处私**患有阴道炎症。
那么,如果我们平时想要预防妇科疾病,贴身的内衣*裤内**尽量一天一换,而且在清洗时也要单独专盆专用。但是有部分的女性比较懒惰,经常和袜子*裤内**一起混合清洗。如果本身患有脚气的话,袜子上的真菌可能会沾染到*裤内**上,此时*处私**就会受到感染,从而患上霉菌性阴道炎。

如果真的患上霉菌性阴道炎,大家应该如何正确治疗呢?
三、患上霉菌性阴道炎治疗有5点
霉菌性阴道炎是非常常见的,阴道炎种类是妇科常见疾病。在很多女性的眼里,妇科疾病是一件比较难以启齿的事情,实际上阴道炎这种妇科疾病,大约有75%的女性医生会得过一次,或者说至少得一次。霉菌性阴道炎是阴道炎的一种类型,得了霉菌性阴道炎要正确地处理治疗,这样才能尽快摆脱它。

1、积极治疗
现如今还有很多女性对于妇科治疗是比较抵触的,不喜欢去医院,这其实是一种对自己健康不够关注的表现。如果得了霉菌性阴道炎而不积极的治疗,就会变得越来越严重,生活也会受到更大的影响。在得了阴道炎以后,一定要积极地治疗,在医生的指导和建议下使用药物进行治疗,主要是抗真菌药物,分为外用药物和口服药物。

2、调整饮食作息,加强锻炼
在治疗霉菌性阴道炎期间,最忌食用太多辛辣刺激的食物。而且,鸡蛋、牛肉等热性高蛋白的食物也要少食。因为此类食物会加重炎症,患者应该保持清淡的饮食,调整自己的作息时间,不要熬夜。
同时,也要加强锻炼,毕竟霉菌性阴道炎的引起主因是由于自身体质的抵抗力下降,而导致念珠菌大量繁殖所致。因此,想要治愈阴道炎,就要先调理好自己的身体。

3、平时讲究卫生
得了霉菌性阴道炎以后,一定要讲究*处私**的卫生,每天都要勤换*裤内**,用清水冲洗*处私**。不要用妇科洗液清洗,因为这些妇科洗液并不是大家所想的洗洗更健康。长期下来,反而会破坏*处私**菌群平衡,容易让女性患上阴道炎。
另外,不要把*裤内**和袜子放在一起洗,*裤内**要单独清洗,穿纯棉的宽松*裤内**,洗完后放在太阳下暴晒。

4、保持积极健康的心态
患上霉菌性阴道炎后不要太过于紧张和担心,保持乐观积极的心态。积极配合医生的治疗,口服用药,消灭肠道念珠菌,同时做好护理保健和注意外阴卫生,注意养成良好的生活习惯,适当的释放和缓解自己的压力。

5、定期检查
在霉菌性阴道炎的治疗期间,女性一定要定期地去医院复查,要让医生知道自己的病情相关。有的时候霉菌性阴道炎反复发作,难以治愈,是因为还存在一些其他方面的病症,去做检查就能把这些病症揪出来,找到真正解决问题的方法。

温馨提示:
霉菌性阴道炎的预防及其重要,如果不幸得了这种妇科疾病,就会影响我们的正常的健康生活,所以对霉菌性阴道炎的预防一定要引起我们的关注。那么要做到科学合理的饮食,一天的三顿饭要保持非常有规律的状态,多吃些调理肠胃的食物,这样可以避免消化功能下降,保证营养非常的充足。
[1]杨花.(2022).克霉唑阴道片治疗霉菌性阴道炎的临床疗效观察. 现代养生(06),422-423.
[2]黄晓芸,龚瑶瑛,陈赛春 & 冯庆菁.(2022).乳管镜下介入治疗浆细胞性乳腺炎后复发的危险因素分析. 中国妇幼保健(06),1074-1076.
[3]郭华林 & 贺燕.(2022).中西医结合治疗顽固性霉菌性阴道炎的临床疗效及对症状评分、阴道环境、阴道分泌物相关因子的影响. 中医研究(03),20-24.